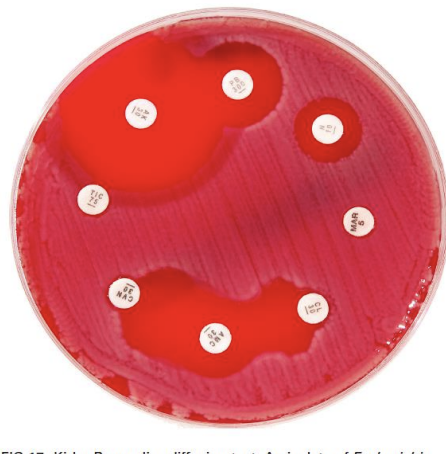
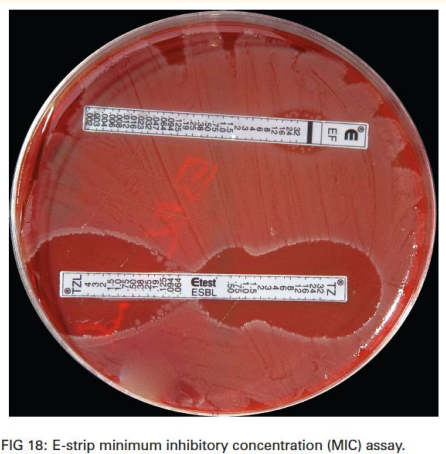

1/34
Looks like no tags are added yet.
Name | Mastery | Learn | Test | Matching | Spaced |
|---|
No study sessions yet.
how do you evaluate depth of pyoderma
Surface & superficial: erythema, exudate, pruritus • Deep: pain, haemorrhage, swelling
Seborrhoeic pyodermas
bacterial overgrowth syndrom— surface
Diffuse erythema, scales and a greasy, keratoseborrhoeic exudate; often pruritic and malodouress
folds, chronic inflammation
add intertrigo?
Skin fold infection; moist, greasy & erythematous,
with or without a malodorous exudat
Papules, pustules, epidermal collarettes & scaling, focal alopecia
name 3 type
name thei clinical presentation
non haemprrhagic as no bv in epidermis
Superficial bacterial folliculitis
Non-follicular pustules; often large and flaccid or
tense (bullous impetigo)
Impetigo
Small, follicular pustules, papules, erythematous
macules, epidermal collarettes, and patchy tufting
of the coat with multi-focal alopecia
Superficial spreading pyoderma
Large, spreading and coalescing epidermal
collarettes, erythema and exfoliation
staph, folliculitis, papules
multifollicularl: pemphicus folliacous
focal: staph
add specific above
Erosions and ulcers
Pyotraumatic dermatitis (self traumatise, strich strat corneum)
Intertrigo (body fold)
AD, steroid + antiseptic
add
add see notes
Deep pyoderma dermis or deeper tissue (rupture of hair follicle),
A superficial, exudative, highly pruritic and painful
infection caused by repeated self-trauma; well-
defined moist erosions, with or without folliculitis
or furunculosis in the surrounding haired skin
furunculosis— deep (2dry
Nodules or regional swelling
Abscess— deep
Diffuse and poorly-circumscribed infection and inflammation; painful and may have a bloody
serous to purulent exudate
Celllulitis— deep
Discrete, swollen, walled off accumulations of pus; often drain purulent fluid and form crusts
us eof cytology in Diagnosis of pyoderma (2)
cytology to confirm diagnosis
use C+C. to ID sensititvity
descripte how to collect representative samples
epidermal collarete: leading edge of sace
pustule: pus in fresh leisinofuruncuosis: deeper— fresh subcut dermal material
cat skin erosion moist—> staph in subcut

name this infection

Staphylococcal pyoderma
staph form a. pair: 2 axis. form bunch

rods— gram -ve (pseudo, endo etc)
wanna do more culture, less susceptible

bacterial overgrowth syndrom
nede torecognise staph, malassezia, rods
empitical choice of anitbiotic
what rules
Not life-threatening – 1 st infection within 3 months – Surface or superficial infection – Predictable antibiotic susceptibility – Antibiotic resistance not likely
appropriate for topical
approapriate for immmediate theapy of life-threa
Bacterial culture & sensitivity indication
Life-threatening infections • Deep or complex infections • Clinical signs and cytology not consistent • Rod or unusual bacteria on cytology • Empirical antibiotics not effective • Antibiotic resistance likely
risk factor of AMR infection
Multiple broad-spectrum antibiotic courses • Antibiotic treatment within 3 months • Non-healing wounds • Post-operative infections • Nosocomial infections • Treatment failure
when to start treametn?
start immediately only if clinically necessary – Look at cytology and likely sensitivity • Escalate treatment to a higher antibiotic tier if resistance present • De-escalate to a lower tier drug or stop treatment if possible
mino staph, staph funniculitis persistant, post op cellulitis, whole limb
Kirby-Bauer discs
MIC
re-visit the breakpoint
highest effective conc of tissue at site of infecct
define breakpoints: sensitive, ressitant, intermediate

Breakpoint:MIC index/ratio

always go fr the higher breakpoint mic ration as most susceptible
MIC = lowest concentration of antibiotic that prevented bacterial growth • The tissue concentration needs to match or exceed the MIC • Tissue concentrations < MIC are sub-therapeutic
Culture results and topical therapy
DO NOT USE CULTURES TO SELECT TOPICAL ANTIBIOTICS
then what do we use????
when is systemic treatment not required
what do you do then?
mild, non-life threatening, focal surface or superficial infections
Manage the primary disease – Consider topical antimicrobials – Consider topical antibiotics
MRSA pesistant infection
biofilm cleaning
reisstant fusidic acid for gram +ve bacteria HIGH CONC
name some topical you can use antiseptic
Hypochlorous acid MICs & MBCs
Other topical antimicrobials
chloorhexidine
CHlorhexidine
efficayr and availability is good
first line sntiseptive.
As effective as systemic amoxicillin-clavulanate – Effective against AMR bacteria – Effective against biofilms – Residual activity on skin & hairs • Can be drying and sensitising
switch to other product that are not drying
works less on super pseudomona (0 effect) and ESL
Hypochlorous acid MICs & MBCs
tissue safe but efficay to clean wound
No residual activity – use at least once daily

Other topical antimicrobials
Polihexanide, hydrogen peroxide, povidone iodine & sodium hypochlorite • Micronised silver • Manuka honey • Essential fatty acids & plant oils • Antimicrobial peptides
ask about ingredient
topical antibiotic used in
focal lesions • Can be effective against AMR bacteria • Silver sulfadiazine – Additive with aminoglycosides & fluoroquinolones • Fusidic acid (goof for gram +ve mrsa) • Mupirocin (check if reserved fro human)
give adveantaege of first line 4
Well established and well tolerated – Good evidence of efficacy – Good evidence of safety • Anti-staphylococcal activity • No less potent than 2nd & 3rd line drugs • Appropriate for empirical treatment
give example of first line

Second line antibiotics
• Broad spectrum drugs important for animals and humans – Resistance of greater concern • Should only be used when there is culture or clinical evidence that first line drugs will not be effective
give example
Cefovecin, cefpodoxime • Enrofloxacin, marbofloxacin, orbifloxacin, difloxacin, pradofloxacin
third line indication
Culture evidence of sensitivity • No 2nd line antibiotics are effective • Topical antimicrobial therapy is not effective or feasible. multidrug resistant organism
Aminoglycosides, chloramphenicols, 3rd and 4th generation cephalosporins, anti-Pseudomonas penicillins, rifampin
fluo aminnoglycovide dose dedpendatn
cephosporin time dependace
tertramycine, ___,___ are untder curve
tissue penetration

use of steroid:
describe clincal cure
surface and superficial pryoderma: how long dows it need
deep pyoderma oftern inproved in ___, full resolution _____
Resolution of lesions and normal cytology • Surface & superficial pyodermas usually 1-3 weeks • Deep pyodermas often improved in 2 weeks – Full resolution may take 4-6 weeks or longer